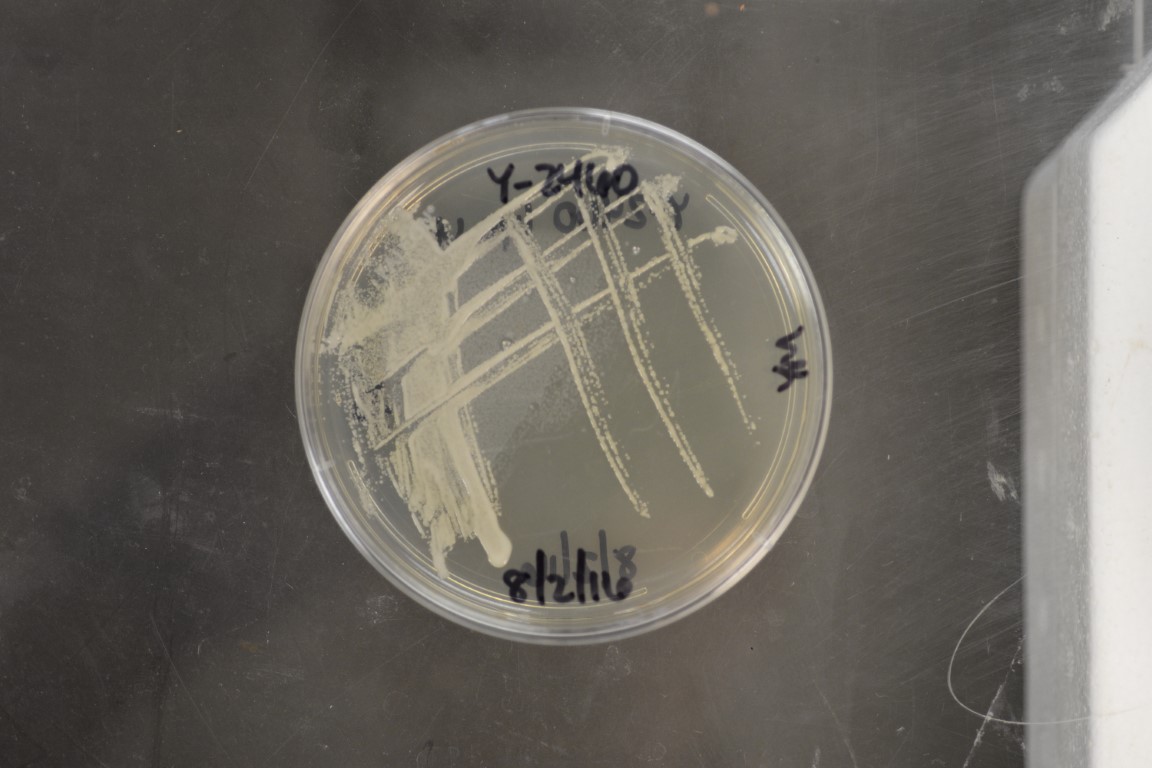

Pachysolen tannophilus
NRRL Y-2460(Type Strain)
Accession numbers in other collections:ATCC 32691=CBS 4044=CCRC 20329=CCY 53-1-1=DBVPG 6666=IGC 4140=IMI 344640=IRIC 145=JCM 31685=MUCL 31901=NCYC 614=NRC 2690=NRRL Y-12749
Source:Boidin,Lyon,France
Isolated from(substrate):TNF,tanning fluid,extract of chestnut(Castanea vesca)
Substrate location:Ludwigshafen,Germany
Genetic info:Robnett PCR#523 from Model E prep,GB U76346.GenBank:D1/D2(JQ689056),SSU(EU011721)(JQ698920),EF-1 alpha(EU014751)(JQ699083),RPB1(JQ713067),RPB2(JQ698999),LSU(EU011641),mito SSU(EU018541).
Growth media:Yeast Extract-Malt Extract-Peptone-Glucose(YM for yeasts)(number 6)
Optimum growth temperature:25C
Strain images:
NRRL_Y-2460_6.JPG